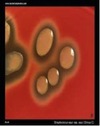

Test 1 Flashcards
(359 cards)
DNA sequence analysis of this structure is widely used in bacterial phylogenetic analysis.
Ribosome
Which one of the following is a cell wall component unique to bacteria?
Peptidoglycan
Bacteria
Prokaryotes (No nucleus) • Complex cell wall • No sterol • Membrane bound organelles are absent • A single circular chromosome (exceptions ?) and no histones • Ribosomes (smaller) 70s • No cytoskeleton • Asexual reproduction (binary fission)
Gram Postive Bacteria
Thick peptidoglycan
Gram negative bacteria
outer membrane, which contains lipopolysacciride - has a Lipid A(endotoxin) component
Mycobacteria
has mycolic acid in the membrane, which is why it stains positive in the acid-fast stain
Gram Staining
-based on peptioglycan thickness • Crystal violet- Primary stain • Gram’s Iodine- Mordant • Decoloriser-Acid Alcohol • Safranin-Counter stain • Gram Positive stain violet/blue( retains Crystal violet) • Gram negative stains Pink(safranin)
What is the cause of many clincial signs of Gram negative bacteria?
Lipid A or endotoxin( a component of the cell wall) Endotoxin binds to macrophage receptors and stimulates an inflammotory cascade
Test for Endotoxin
Limulus Amebocyte Lysate(LAL); everything has to be checked for endotoxin
Which are the bacteria that does not contain peptidoglycan
Mycoplasmia and Chlomydia
Flagella
Locomotion / Motility Number and arrangement can be used for identification
Endoflagella
Flagella inside the cell Endoflagella /axial filaments in the periplasmic space eg. spirochetes
Pili/ fimbriae
• Pili/ fimbriae: Small thread like structures • Facilitate adherence to the host tissue • Contribute to antigenicity Eg: Bordetella bronchiseptica, E.coli
K88
Neonatal piglets-Fimbrial antigens in E.coli
K99
Neonatal calves-Fimbrial antigens in E.coli
Capsule
Polysaccharide outer coating of the bacteria - Helps organisms to evade phagocytosis
Which bacterial species has a non-polysaccharide capsule?
Bacillus anthracis, thus staining for this capsule is how we ID this bacteria
Endospores
Produced when essential nutrients are depleted in a bacteria - or under BAD conditions as the spores are very virulent to poor conditions Organic acid called Dipicolinic acid protects the endospore from damage Eg: Clostridium, Bacillus THESE AID IN BACTERIAL SURVIVAL
aerobic, microaerophilic, capnophilic
Oxygen required for growth
obligate anaerobe, aerotolerant anaerobe
Oxygen not required or utilized for growth
facultative anaerobe
Oxygen not required but can be utilized for growth
Bacterial Virulence Factors
properties or traits found in isolates that cause disease but which are not found in isolates of the same species that lack ability to cause disease
Damage caused by bacteria
Damage caused by bacteria Using the host’s nutrients Direct damage to the host cell (Toxins) Hypersensitivity reactions (Type IV Hypersensitivity- Tuberculosis)
Pathogenicity
Pathogenicity is the ability of a pathogen to produce a disease by overcoming the defense mechanisms of the host.